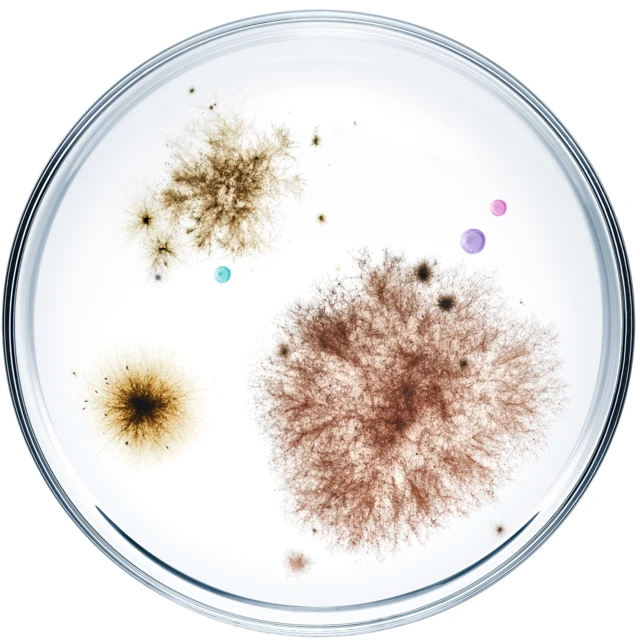
Microbes

We’re here to better our world with biology and we need your help. Novonesis is the world’s leading biosolutions partner and we’re looking for change-makers within all fields and from all backgrounds. Future colleagues that want to join a workplace filled with respect, challenge, and a commitment to doing what matters for each other and the planet.
We are the biological choice.

Novonesis by the numbers
Employees
Commercial industries
Countries
Explore our culture and philosophy
Take a closer look at the values and philosophies that make us who we are

Find your role at Novonesis
Our roles and responsibilities can be categorized into 12 main areas. We’re always looking for ambitious change-makers and those who want to make the world a better place with biology. Explore our 12 key areas and job opportunities below.

Research & Development
Innovate and develop new biosolutions and improve existing ones

Commercial
Promote and sell Novonesis solutions and services

Production
Manufacture and produce high-quality biosolutions products efficiently

Information Technology
Provide and manage technology solutions that support our business

Quality
Ensure that products meet regulatory and quality standards

Supply Chain Management
Manage the end-to-end supply chain processes

Finance
Manage the company’s financial resources and ensure compliance

People & Organization
Attract, develop and retain talent while fostering organizational culture

Communications & External Engagement
Manage and enhance the company’s image and relationships

General Management & Administration
Oversee and coordinate the overall business operations

Procurement
Source, purchase, receive and inspect the goods we need to operate

Legal
Provide legal support and ensure compliance
Three reasons to choose Novonesis
Be you
All of us at Novonesis share something special, a deep-rooted respect for one another and our planet. Here, being yourself isn’t just expected - it’s encouraged. This is a place where you can belong.

Be better
We want to bring out the best in you. In Novonesis, we are committed to nurture motivation and growth. Here, you’ll be surrounded by dedicated leaders and inspiring colleagues that are ready to support you in succeeding with your role in our shared purpose.

Be ahead
When you pursue a career at Novonesis, you will be ahead of the curve. We are more than 100 years old and the world’s leading biosolutions partner. Here you can create a positive impact on the world around you. We believe that the opportunities for you and our biosolutions are endless.

Standing on the shoulders of giants
We may be a new company, but we’ve got a big head start.
Novonesis was created from the combination of Chr. Hansen and Novozymes, two of the world’s leading biosolutions providers with more than 125 years of combined experience and over 10,000 people with a passion for making a difference.
Through our knowledge and dedication, we help our customers and partners transform production and consumption with the power of biology.